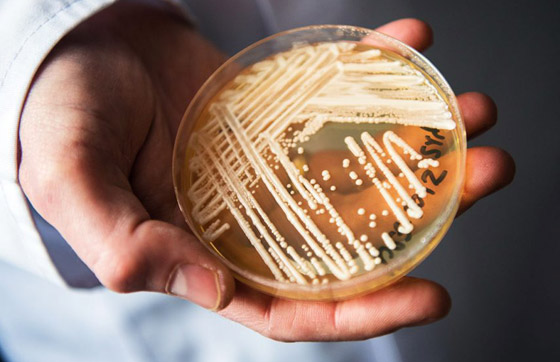

أعلن مسؤولو الصحة في ولاية أوريغون عن ثلاث حالات من فطر داء البقع البيضاء، وهي عدوى نادرة وصفتها مراكز السيطرة على الأمراض والوقاية منها (CDC) بأنها تشكل مصدر قلق "خطير" للعالم. وأكد المسؤولون الحالات الثلاث في ولاية أوريغون الأميركية، الثلاثاء الماضي، وهي الأولى في الولاية. واكتشفت الحالة الأصلية في 11 ديسمبر/كانون الأول، بينما عثر على الحالتين الأخريين في الأسابيع التالية. واندلع التفشي في Salem Health في Salem بولاية أوريغون.
وكشف عن الحالة الأولى في مريض "تعرض للرعاية الصحية الدولية مؤخرا"، وفقا للمسؤولين. وتعرف الباحثون على حالة فطر داء البقع البيضاء (Candida auris) لأول مرة في عام 2009، لكنها لم تظهر في الولايات المتحدة حتى عام 2013. ومنذ ذلك الحين عثر مركز السيطرة على الأمراض على أكثر من 1100 حالة سريرية إيجابية للعدوى، والتي تشمل كلا من الحالات المؤكدة والمحتملة، وفقا لموقعهم على الإنترنت. وأبلغت تكساس ونيويورك وإلينوي وكاليفورنيا وفلوريدا عن معظم الحالات، والتي تتراوح من 135 إلى 285.
ووفقا لمراكز السيطرة على الأمراض والوقاية منها، فإن عدوى فطر داء البقع البيضاء "تمثل تهديدا عالميا خطيرا" وتنتشر في الغالب محليا من خلال مرافق الرعاية الصحية. ويوصف الفطر بأنه شديد العدوى ويمكن أن يسبب "عدوى غازية" شديدة في 5-10% من المصابين. ويمكن أن تشمل الأعراض الحمى والقشعريرة، ويمكن للفطر أن ينتشر عبر المناطق الملوثة أو عن طريق الاتصال الوثيق مع شخص مصاب به.

وقالت ياسمين تشودري، المدير الطبي للوقاية من العدوى في Salem Health، في أحدث إعلان أن جائحة "كوفيد-19" أدى إلى "ارتفاع في الكائنات الحية المقاومة للأدوية المتعددة" مثل Candida auris. وحذر مسؤولو الصحة في ولاية أوريغون من أن العدوى "بشكل خاص" تسبب التهابات خطيرة لأولئك الذين يعانون بالفعل من "مشاكل طبية خطيرة".




